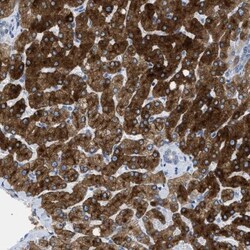
ASGPR1 Antibody, Novus Biologicals 25 &mu;L; Unlabeled:Anticorps, Polyclonal

missing translation for 'onlineSavingsMsg'
Learn More
Learn More
ASGPR1 Antibody, Novus Biologicals™
Rabbit Polyclonal Antibody has been used in 1 publication
Marque: Novus Biologicals NBP1-85581-25ul
Les retours ne sont pas autorisés pour ce produit.
Afficher la politique du retour.
Description
ASGPR1 Polyclonal specifically detects ASGPR1 in Human samples. It is validated for Western Blot, Immunohistochemistry, Immunocytochemistry/Immunofluorescence, Immunohistochemistry-Paraffin.
Spécification
| ASGPR1 | |
| Polyclonal | |
| Western Blot 0.04 - 0.4 ug/ml, Immunohistochemistry 1:500 - 1:1000, Immunocytochemistry/Immunofluorescence 0.25-2 ug/ml, Immunohistochemistry-Paraffin 1:200-1:500 | |
| ASGPR, ASGPR 1, ASGP-R 1, asialoglycoprotein receptor 1, CLEC4H1ASGPR1, C-type lectin domain family 4 member H1, Hepatic lectin H1, HL-1 | |
| Rabbit | |
| Affinity Purified | |
| RUO | |
| Primary | |
| Specificity of antibody verified on a Protein Array containing target protein plus 383 other non-specific proteins. | |
| Store at 4C short term. Aliquot and store at -20C long term. Avoid freeze-thaw cycles. |
| Western Blot, Immunohistochemistry, Immunocytochemistry, Immunofluorescence, Immunohistochemistry (Paraffin) | |
| Unconjugated | |
| PBS (pH 7.2) and 40% Glycerol with 0.02% Sodium Azide | |
| ASGR1 | |
| This antibody was developed against Recombinant Protein corresponding to amino acids:MTKEYQDLQHLDNEESDHHQLRKGPPPPQPLLQRLCSGPRL | |
| 25 μL | |
| Immunology, Virology Bacteria and Parasites | |
| 432 | |
| Human | |
| IgG |
Correction du contenu d'un produit
Veuillez fournir vos retours sur le contenu du produit en remplissant le formulaire ci-dessous.
Nom du produit
For Research Use Only
Vous avez repéré une opportunité d'amélioration ?Partager une correction de contenu